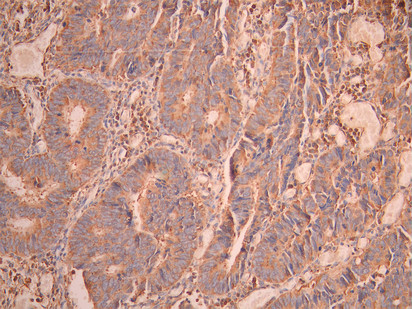

SCARB2 Recombinant Monoclonal Antibody
-
中文名稱:SCARB2 Recombinant Monoclonal Antibody
-
貨號:CSB-RA203929A0HU
-
規格:¥1320
-
圖片:
-
Western Blot
Positive WB detected in: Hela whole cell lysate(30μg), MCF7 whole cell lysate(30μg), HEK293 whole cell lysate(30μg), PC-3 whole cell lysate(30μg), A549 whole cell lysate(30μg), U251 whole cell lysate(30μg), COLO205 whole cell lysate(30μg), Mouse brain tissue lysate(30μg), Rat brain tissue lysate(30μg)
All lanes:SCARB2 antibody at 1:1000
Secondary
Goat polyclonal to rabbit IgG at 1/40000 dilution
Predicted band size: 54 kDa
Observed band size: 77 kDa
Exposure time:1min -
IHC image of CSB-RA203929A0HU diluted at 1:100 and staining in paraffin-embedded human liver tissue performed on a Leica BondTM system. After dewaxing and hydration, antigen retrieval was mediated by high pressure in a citrate buffer (pH 6.0). Section was blocked with 10% normal goat serum 30min at RT. Then primary antibody (1% BSA) was incubated at 4°C overnight. The primary is detected by a Goat anti-rabbit polymer IgG labeled by HRP and visualized using 0.05% DAB.
-
IHC image of CSB-RA203929A0HU diluted at 1:100 and staining in paraffin-embedded human colorectal cancer performed on a Leica BondTM system. After dewaxing and hydration, antigen retrieval was mediated by high pressure in a citrate buffer (pH 6.0). Section was blocked with 10% normal goat serum 30min at RT. Then primary antibody (1% BSA) was incubated at 4°C overnight. The primary is detected by a Goat anti-rabbit polymer IgG labeled by HRP and visualized using 0.05% DAB.
-
Overlay Peak curve showing A431 cells stained with CSB-RA203929A0HU (red line) at 1:100. The cells were fixed in 4% formaldehyde and permeated by 0.2% TritonX-100 for 10min. Then 10% normal goat serum to block non-specific protein-protein interactions followed by the antibody (1ug/1*106cells) for 45min at 4℃. The secondary antibody used was FITC-conjugated goat anti-rabbit IgG (H+L) at 1/200 dilution for 35min at 4℃.Control antibody (green line) was Rabbit IgG (1ug/1*106cells) used under the same conditions. Acquisition of >10, 000 events was performed.
-
-
其他:
產品詳情
-
Uniprot No.:
-
基因名:
-
別名:85 kDa lysosomal membrane sialoglycoprotein antibody; 85 kDa lysosomal sialoglycoprotein scavenger receptor class B member 2 antibody; AMRF antibody; CD36 antibody; CD36 antigen (collagen type I receptor; thrombospondin receptor)-like 2 (lysosomal integral membrane protein II) antibody; CD36 antigen antibody; CD36 antigen-like 2 antibody; CD36L2 antibody; EPM4 antibody; HLGP85 antibody; LGP85 antibody; LIMP 2 antibody; LIMP II antibody; LIMP2 antibody; LIMPII antibody; Lysosomal integral membrane protein II antibody; Lysosome membrane protein 2 antibody; Lysosome membrane protein II antibody; OTTHUMP00000160590 antibody; OTTHUMP00000219176 antibody; Scarb2 antibody; Scavenger receptor class B member 2 antibody; Scavenger receptor class B; member 2 antibody; SCRB2_HUMAN antibody; SR BII antibody; SRBII antibody
-
反應種屬:Human, Mouse, Rat
-
免疫原:A synthesized peptide from human SCARB2 protein
-
免疫原種屬:Homo sapiens (Human)
-
標記方式:Non-conjugated
-
克隆類型:Monoclonal
-
抗體亞型:Rabbit IgG
-
純化方式:Affinity-chromatography
-
克隆號:12F9
-
濃度:It differs from different batches. Please contact us to confirm it.
-
保存緩沖液:Rabbit IgG in 10mM phosphate buffered saline , pH 7.4, 150mM sodium chloride, 0.05% BSA, 0.02% sodium azide and 50% glycerol.
-
產品提供形式:Liquid
-
應用范圍:ELISA, WB, IHC, FC
-
推薦稀釋比:
Application Recommended Dilution WB 1:500-1:5000 IHC 1:50-1:200 FC 1:50-1:200 -
Protocols:
-
儲存條件:Upon receipt, store at -20°C or -80°C. Avoid repeated freeze.
-
貨期:Basically, we can dispatch the products out in 1-3 working days after receiving your orders. Delivery time maybe differs from different purchasing way or location, please kindly consult your local distributors for specific delivery time.
-
用途:For Research Use Only. Not for use in diagnostic or therapeutic procedures.
相關產品
靶點詳情
-
功能:Acts as a lysosomal receptor for glucosylceramidase (GBA) targeting.; (Microbial infection) Acts as a receptor for enterovirus 71.
-
基因功能參考文獻:
- Crystal structure of a LIMP-2 luminal domain dimer with bound cholesterol and phosphatidylcholine is described. Binding of these lipids alters LIMP-2 from functioning as a glucocerebrosidase-binding monomer toward a dimeric state that preferentially binds anionic phosphatidylserine over neutral phosphatidylcholine. PMID: 29199275
- The binding of a monoclonal antibody to the apical region of SCARB2 blocks EV71 infection. PMID: 28447294
- The findings identify SR-BII as a functional SAA receptor that mediates SAA uptake and contributes to its proinflammatory signaling via the MAPK-mediated signaling pathways. PMID: 28423002
- In this paper we provide an updated overview of the clinical and genetic features of SCARB2-related PME and on the functions of the LIMP2 protein [review] PMID: 27582254
- neutrophils are able to drive a macrophage activation that would regulate the increase in LIMP-2 expression during the early phase of Cer-induced acute pancreatitis PMID: 26794464
- Findings suggested that STX1B rs4889603, FAM47E rs6812193 and SCARB2 rs6825004 do not confer a significant risk for Parkinson's disease PMID: 26224037
- LIMPII was increased greater than twofold in urinary microvesicles obtained from patients with idiopathic membranous nephropathy compared to microvesicles of patients with idiopathic focal segmental glomerulosclerosis and normal controls. PMID: 26304790
- Although hrGCase cellular uptake is independent of LIMP-2, its trafficking to the lysosomes is mediated by this receptor. PMID: 26018676
- SNCA and SCARB2 loci are also associated with dementia with Lewy bodies, after a study-wise Bonferroni correction, although these have a different association profile than the associations reported for the same loci in Parkinson's. PMID: 24973356
- a novel mutation in SCARB2 as a cause of progressive myoclonus epilepsy in China PMID: 24620919
- SCARB2 regulates TLR9-dependent IFN-I production of plasmacytoid dendritic cells PMID: 25862818
- Disease-causing cathepsin-F mutants fail to cleave LIMP-2. Our findings provide evidence that LIMP-2 represents an in vivo substrate of cathepsin-F with relevance for understanding the pathophysiology of type-B-Kufs-disease. PMID: 25576872
- Data indicate that scavenger receptor SCARB2 triggers uncoating of human enterovirus 71 (EV71) under low pH conditions. PMID: 24986489
- SCARB2 and PSGL-1 in human gastrointestinal tract, lung, and brain tissues correlated with the distribution of pathological changes seen in EV71 infection. PMID: 24997419
- In LIMP-2-deficient brains a significant reduction in GC activity led to lipid storage, disturbed autophagic/lysosomal function, and alpha-synuclein accumulation. PMID: 25316793
- The LIMP-2/SCARB2 binding sequences for enterovirus 71 and GCase are not similar, indicating that LIMP-2/SCARB2 may have multiple or overlapping binding sites with differing specificities. PMID: 25202012
- A novel SCARB2 mutation was indicated by reduced Beta-glucocerebrosidase activity in progressive myoclonus epilepsy. PMID: 24485911
- Mutations in LIMP-2, the specific receptor for glucocerebrosidase that is missing in Gaucher disease patients, substantially contribute to the pathology and heterogeneity of the disease. (Review) PMID: 24389070
- study of two Japanese siblings with late-onset progressive myoclonus epilepsy without renal failure having a novel homozygous SCARB2 mutation PMID: 23325613
- Human SCARB2-transgenic mice are a useful model for assessing anti-EV71 medications. PMID: 23451246
- Results suggest that this hSCARB2 transgenic mouse could represent a useful animal model for the study of enterovirus 71 (EV71) infection. PMID: 23959904
- identified no novel exonic variants in SCARB2 but confirmed the association between SNP rs6812193 and Parkinson's disease. PMID: 23408458
- SCARB2 is implicated in the lysosomal pathway recently associated with Parkinson disease (PD) pathogenesis. The rs6812193 polymorphism doesn't increase susceptibility to PD in the Greek population. PMID: 23473716
- These results indicated that SCARB2 is capable of viral binding, viral internalization, and viral uncoating and that the low infection efficiency of L-PSGL1 cells is due to the inability of PSGL1 to induce viral uncoating. PMID: 23302872
- Lysosomal storage disorders are associated with deficiencies of alternative lysosomal receptors LIMPII and sortilin and/or of their cargos. (Review) PMID: 22884962
- H171 residue in LIMP-2 is necessary for LIMP-2 and beta-glucocerebrosidase binding PMID: 22537104
- Our data do not support the association of SNP rs6812193 with PD in Han Chinese of mainland China. PMID: 22465138
- Two sisters are described with action myoclonus-renal failure (AMRF) syndrome resulting from a mutation in the SCARB2 gene. PMID: 21782476
- This study supported a genetic contribution of the SCARB2 locus to PD; future studies in larger cohorts are necessary to verify this finding. PMID: 22223122
- Coxsackievirus A infection is via celluar virus receptor SCARB2. PMID: 22438546
- Results show that EV71 binds to SCARB2 and triggers a clathrin- and dynamin-dependent endocytosis for its entry. PMID: 22272359
- Sequencing of SCARB2 genomic and cDNA identified a heterozygous, maternally inherited novel mutation (SCARB2 ) PMID: 21796727
- The residues between 144 and 151 are critical for SCARB2 binding to VP1 of EV71 and seven residues from the human receptor could convert murine SCARB2, an otherwise inefficient receptor, to an efficient receptor for EV71 viral infection. PMID: 22219187
- We showed that just four genes, G3BP2, SCARB2, CSNK1A1 and SPRR2B, can classify patients as presence of lymph node metastasis negative or positive, with 80.0% accuracy. PMID: 21985131
- in rare cases heterozygous SCARB2 mutations may be associated with demyelinating polyneuropathy features. PMID: 22032306
- This study demonistrated that patients with SCARB2 mutations showed the clinical and neurophysiologic phenotype of progressive myoclonus epilepsy , extending the spectrum reported in the typical action myoclonus renal failure syndrome. PMID: 22050460
- L929 cells expressing chimeras that carried amino acids 142 to 204 from the human sequence were susceptible to enterovirus 71, while chimeras that carried the mouse sequence in this region were not. PMID: 21389126
- Action Myoclonus-Renal Failure Syndrome-causing mutations within LIMP-2 affect the binding to beta-glucocerebrosidase. PMID: 19933215
- Several putative signalling motifs identified in the C-terminus of human SR-BII, which are absent from SR-BI, interact with signalling molecules to mobilize stored cholesteryl esters and/or promote the efflux of intracellular free cholesterol. PMID: 14570588
- High density lipoprotein endocytosis by scavenger receptor SR-BII is clathrin-dependent and requires a carboxyl-terminal dileucine motif. PMID: 16368683
- Residues favoring AP3 binding introduced into a protein that is transported via the PM such as the invariant chain can re-route such protein into direct sorting to late endosomal/lysosomal structures. PMID: 16542748
- SCARB2/Limp2 has pleiotropic effects that may be relevant to understanding the pathogenesis of other forms of glomerulosclerosis or collapse and myoclonic epilepsies. PMID: 18308289
- Scavenger receptor B2 is a cellular receptor for enterovirus 71. PMID: 19543282
- Study of SCARB2 mutations finds unsolved cases of progressive myoclonus epilepsy without renal impairment, especially those resembling Unverricht-Lundborg disease. PMID: 19847901
- Functional analysis of the mouse homolog PMID: 12620969
顯示更多
收起更多
-
相關疾?。?/div>Epilepsy, progressive myoclonic 4, with or without renal failure (EPM4)亞細胞定位:Lysosome membrane; Multi-pass membrane protein.蛋白家族:CD36 family數據庫鏈接:
Most popular with customers
-
-
YWHAB Recombinant Monoclonal Antibody
Applications: ELISA, WB, IHC, IF, FC
Species Reactivity: Human, Mouse, Rat
-
Phospho-YAP1 (S127) Recombinant Monoclonal Antibody
Applications: ELISA, WB, IHC
Species Reactivity: Human
-
-
-
-
-